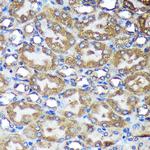
ACTR1B Antibody in Immunohistochemistry (Paraffin) (IHC (P))

Search
Invitrogen
ACTR1B Polyclonal Antibody
{{$productOrderCtrl.translations['antibody.pdp.commerceCard.promotion.promotions']}}
{{$productOrderCtrl.translations['antibody.pdp.commerceCard.promotion.viewpromo']}}
{{$productOrderCtrl.translations['antibody.pdp.commerceCard.promotion.promocode']}}: {{promo.promoCode}} {{promo.promoTitle}} {{promo.promoDescription}}. {{$productOrderCtrl.translations['antibody.pdp.commerceCard.promotion.learnmore']}}
图: 1 / 4
ACTR1B Antibody (PA5-116639) in IHC (P)

Please note: We are reviewing Western blot images included in the antibody testing data in our catalog, including those provided by third parties. Unless expressly labeled or annotated as “raw-unedited”, Western blot images included in the antibody testing data in our catalog may have been edited, optimized or otherwise adjusted for presentation.
产品信息
PA5-116639
种属反应
宿主/亚型
分类
类型
抗原
偶联物
形式
浓度
规格
纯化类型
保存液
内含物
保存条件
运输条件
RRID
产品详细信息
Positive Samples: Mouse thymus, Mouse brain, Mouse heart, Rat lung
Immunogen sequence: MESYDIIANQ PVVIDNGSGV IKAGFAGDQI PKYCFPNYVG RPKHMRVMAG ALEGDLFIGP KAEEHRGLLT IRYPMEHGVV RDWNDMERIW QYVYSKDQLQ TFSEE
靶标信息
This gene encodes a 42.3 kD subunit of dynactin, a macromolecular complex consisting of 10 subunits ranging in size from 22 to 150 kD. Dynactin binds to both microtubules and cytoplasmic dynein and is involved in a diverse array of cellular functions, including ER-to-Golgi transport, the centripetal movement of lysosomes and endosomes, spindle formation, chromosome movement, nuclear positioning, and axonogenesis. This subunit, like ACTR1A, is an actin-related protein. These two proteins, which are of equal length and share 90% amino acid identity, are present in a constant ratio of approximately 1:15 in the dynactin complex.
⚠WARNING: This product can expose you to chemicals including mercury, which is known to the State of California to cause birth defects or other reproductive harm. For more information go to www.P65Warnings.ca.gov.
仅用于科研。不用于诊断过程。未经明确授权不得转售。
篇参考文献 (0)
生物信息学
蛋白别名: Actin-related protein 1B; ARP1; ARP1 actin-related protein 1 homolog B, centractin beta; ARP1B; Beta-centractin; yeast homolog B
基因别名: 2310066K23Rik; AA960180; ACTR1B; AI851923; Arp1b; CTRN2
UniProt ID: (Mouse) Q8R5C5
Entrez Gene ID: (Rat) 316333, (Mouse) 226977




